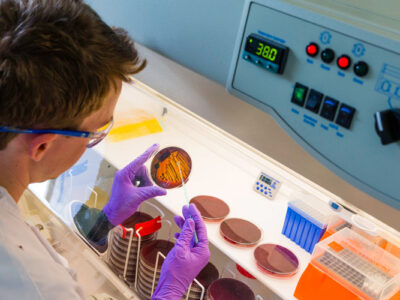
аналіз калу на дисбіоз та лабораторна оцінка мікробіоти кишківника

Меділаб Плюс – швидкі та точні аналізи у Хмельницькому та інших містах



Відео Меділаб Плюс

Блог Меділаб Плюс
Цікаво знати
Аналізи у “Меділаб Плюс” – точні результати за 1 день
Здоров’я – найцінніший ресурс, і його контроль починається з якісної діагностики. “Меділаб Плюс” – це сучасна медична лабораторія, що надає широкий спектр аналізів у Хмельницькому та інших містах. Ми гарантуємо точність результатів, швидке виконання та зручність для кожного клієнта.
Чому обирають “Меділаб Плюс”?
Швидке отримання результатів
Ми розуміємо, наскільки важливо отримати аналізи вчасно. Саме тому більшість результатів доступні вже протягом одного дня після здачі.
Висока точність досліджень
Лабораторія використовує сучасне обладнання та міжнародні стандарти контролю якості, що дозволяє отримувати максимально точні та достовірні результати.
Доступні ціни
Ми прагнемо зробити якісну діагностику доступною для всіх, тому пропонуємо конкурентні ціни та різні варіанти здачі аналізів без зайвих витрат.
Комфорт для клієнтів
Усі лабораторії обладнані комфортними зонами очікування, а процес здачі аналізів максимально швидкий і безболісний. Також доступна опція онлайн-результатів, що дозволяє отримати їх без відвідування лабораторії.
Популярні аналізи у “Меділаб Плюс”
Аналізи крові
Лабораторія виконує загальноклінічні, біохімічні, гематологічні та гормональні аналізи, що допомагають виявити широкий спектр захворювань та оцінити загальний стан організму.
Онкомаркери
Рання діагностика онкологічних захворювань є ключем до своєчасного лікування. Аналізи на онкомаркери дозволяють виявити ризики на ранніх стадіях.
Гормональні дослідження
Зміни у рівні гормонів можуть свідчити про порушення у роботі щитовидної залози, репродуктивної системи та інших органів. Аналізи на гормони допомагають виявити ендокринні порушення та підібрати правильне лікування.
Спермограма
Дослідження сперми є важливим кроком у діагностиці чоловічого безпліддя. Аналіз дозволяє оцінити якість сперматозоїдів та загальний стан репродуктивної системи.
ПЛР-тестування
Метод полімеразної ланцюгової реакції дозволяє з високою точністю виявити наявність вірусних інфекцій, у тому числі COVID-19, ВПЛ та інших патогенів.
Як записатися на аналізи?
Щоб здати аналізи, достатньо записатися онлайн через сайт або відвідати одне з наших відділень без попереднього запису. Всі лабораторії працюють за гнучким графіком, що дозволяє обрати зручний час для відвідування.
Переглянути всі лабораторії та їхній графік роботи можна на сторінці Контакти.
Контроль якості та безпека пацієнтів
“Меділаб Плюс” дотримується міжнародних стандартів контролю якості та забезпечує безпечне середовище для пацієнтів. Всі аналізи проводяться із суворим дотриманням стерильності та відповідно до рекомендацій МОЗ.
Меділаб Плюс – надійна лабораторія аналізів
Наша лабораторія поєднує у собі високу якість досліджень, швидкість виконання та зручність для кожного пацієнта. Ми постійно вдосконалюємо процеси, розширюємо спектр аналізів та відкриваємо нові відділення, щоб бути ще ближче до вас.
Записуйтеся на аналізи та отримуйте точні результати у “Меділаб Плюс” – лабораторії, якій довіряють тисячі людей!